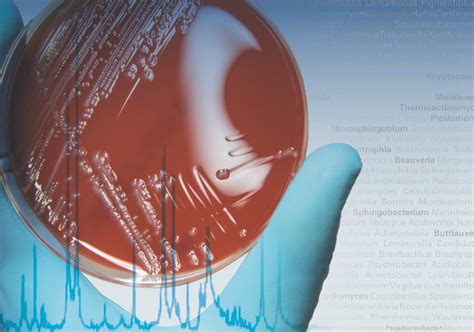

Microbial Identification Methods and Techniques
Microbial Identification FAQ
What is microbial identification?
Microbial identification can be defined as “microbial characterization by a limited spectrum of tests pre-chosen and appropriate to the problem being studied” . This chapter has outlined some of the microbial identification techniques undertaken. The techniques described have been divided between phenotypic and genotypic methods.
How do you identify microorganisms?
There are many ways to detect, characterize, and identify microorganisms. Some methods rely on phenotypic biochemical characteristics, while others use genotypic identification. The biochemical characteristics of a bacterium provide many traits that are useful for classification and identification.
What is Biolog microbial identification?
Microbial identification can be defined as “microbial characterization by a limited spectrum of tests pre-chosen and appropriate to the problem being studied” . The Biolog Microbial Identification System offers a fast and easy way to identify more than 2200 species of both Gram-positive and Gram-negative bacteria, yeast, and filamentous fungi.
How do you test for microbial identification?
Some biochemical tests for microbial identification are quite simple. To test whether bacteria contain a catalase enzyme, a microbiologist drops hydrogen peroxide into a smear of bacteria on a microscope slide. If the bacteria contain catalase, the mixture bubbles as the hydrogen peroxide decomposes into water and oxygen.
Why is microbial identification important?
Microbial identification represents an important part of the microbiology function. This includes screening products for objectionable organisms, profiling the environmental microbiota, and investigating out-of-limits events with a view to assigning a probable point of origin.
Microbial Identification References
If you want to know more about Microbial Identification, consider exploring links below:
What Is Microbial Identification
- https://www.sciencedirect.com/topics/medicine-and-dentistry/microbial-identification
- https://bitesizebio.com/36644/methods-microbial-identification/
- https://asm.org/Articles/2020/February/Identifying-Bacteria-Through-Look,-Growth,-Stain
- https://www.ncbi.nlm.nih.gov/pmc/articles/PMC6560418/
- https://bio.libretexts.org/Courses/North_Carolina_State_University/MB352_General_Microbiology_Laboratory_2021_(Lee)/08%3A_Bacterial_Identification/8.03%3A_Introduction_to_Bacterial_Identification_using_Genotypic_methods
Explore Related Topics
What are the key technologies used in antimicrobial susceptibility testing?
Delve into the various technologies such as automated systems, disk diffusion, and gradient diffusion used in antimicrobial susceptibility testing. Share the advantages, limitations, and future prospects of these technologies in predicting effective antibiotic treatments.